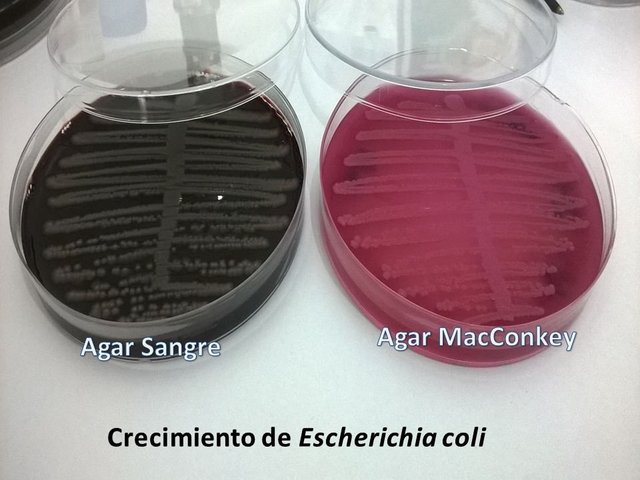
featured

Orimillan (39)
Bioanalista Especialista en Bacteriología Clínica amante a mi pequeño mundo detrás del microscopio
298 followers124 posts185 following2 HP
Blacklisted UsersMuted UsersFollowed BlacklistsFollowed Muted Lists
Blacklisted UsersMuted UsersFollowed BlacklistsFollowed Muted Lists
Venezuela Joined March 2018 Active 8 years ago